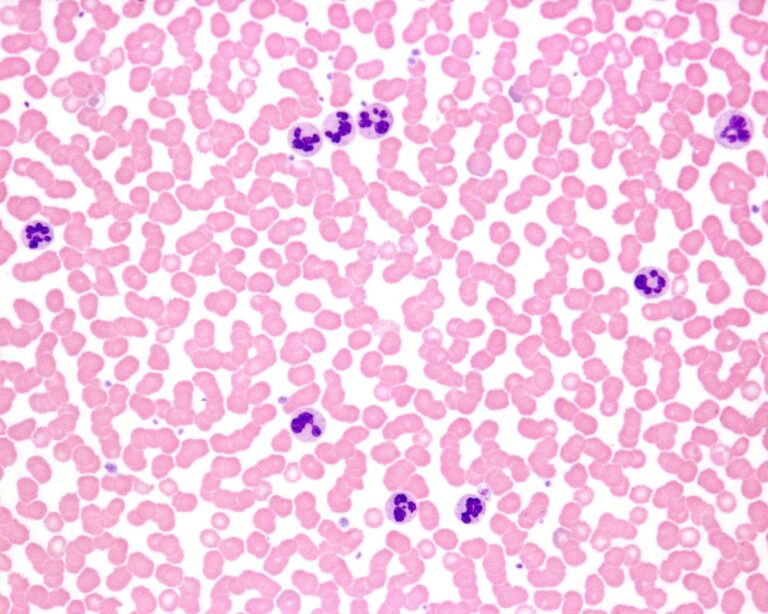
Podwyższony poziom leukocytów we krwi – o czym może świadczyć? Objawy i diagnostyka leukocytozy

Artykuł powstał 15.03.2021 r., ostatnia aktualizacja: 12.01.2026 r.
Zdarzają Ci się dolegliwości brzuszne? Przelewanie, bóle brzucha, biegunki, czy wręcz przeciwnie, zmagasz się z zaparciami? Problemem może być złe trawienie lub nieprawidłowe wchłanianie węglowodanów, które dość często prowadzi do przewlekłych dolegliwości brzusznych o zróżnicowanym nasileniu. Odpowiadają za to z reguły cukry, czyli laktoza, fruktoza i sorbitol.
Spis treści:
- Nietolerancja węglowodanów – co to jest?
- Jakie są przyczyny nietolerancji węglowodanów?
- Klasyfikacja nietolerancji węglowodanów
- Nietolerancja laktozy
- Nietolerancja fruktozy
- Nietolerancja galaktozy – galaktozemia
- Nietolerancja FODMAPS
- Objawy zespołu jelita drażliwego (ZJD) a nietolerancja węglowodanów
- Diagnostyka nietolerancji węglowodanów – testy oddechowe
- Nietolerancja węglowodanów – leczenie
- Zakończenie
- Nietolerancja węglowodanów – FAQ
Nietolerancja węglowodanów – co to jest?
Nietolerancja węglowodanów to stan, w którym proces ich trawienia i wchłaniania w jelicie cienkim jest zaburzony.
W warunkach fizjologicznych, węglowodany z diety (np. skrobia, laktoza, fruktoza, sorbitol) rozkładane są przez enzymy trawienne do cukrów prostych, ponieważ tylko w takiej formie możliwy jest ich transport i przenikanie przez ścianę jelita do krwiobiegu.
Jeśli opisywany wyżej mechanizm jest niesprawny, niewchłonięte w jelicie cienkim węglowodany, przedostają się do dalszych odcinków przewodu pokarmowego, które nie są przygotowane na ich obecność. Wywołuje to kaskadę niepożądanych reakcji, które skutkują objawami chorobowymi.
Nietolerancja węglowodanów – objawy i skutki
Obecność i zaleganie węglowodanów w jelitach powoduje wzrost ciśnienia osmotycznego w świetle przewodu pokarmowego i przyciąganie wody. Jej nagromadzenie rozciąga jelita i przyspiesza perystaltykę. Dodatkowo, niewchłonięte węglowodany, ulegają szybkiej fermentacji przez mikrobiotę jelitową, w wyniku czego powstają gazy, mleczany i krótkołańcuchowe kwasy tłuszczowe. Zjawiska te odpowiadają za typowe objawy kliniczne zgłaszane przez pacjentów: biegunki, wzdęcia, nadmierne gazy oraz bóle brzucha. Nasilenie tych dolegliwości jest kwestią indywidualną i zależy od szeregu czynników, takich jak:
- ilość i jakość spożytych węglowodanów (ocenia się, iż 10 g niewchłoniętego cukru może wytwarzać 1 l gazów),
- tempo opróżniania żołądka,
- motoryka jelit,
- skład mikrobioty bakteryjnej jelita grubego.
Węglowodany rozpuszczone w płynach i wypite na czczo, prowadzą szczególnie szybko do powstania wysokich stężeń cukru w świetle jelita wywołując silne objawy. Ich natężenie może zmieniać się u danego pacjenta w zależności od dnia, np. równoczesne spożywanie warzyw strączkowych lub wysoki udział błonnika w pożywieniu może wywierać dominujący wpływ na reakcje.
Rzadziej występują inne dolegliwości takie jak spadek masy ciała czy objawy niedoboru witamin rozpuszczalnych w tłuszczach.
| Warto pamiętać: Typowe objawy nietolerancji węglowodanów obejmują: biegunkę, wzdęcia, gazy, bóle brzucha. |
Na obraz kliniczny nietolerancji węglowodanów u danego pacjenta mają także wpływ niektóre schorzenia, takie jak nadczynność tarczycy, depresja czy czynniki towarzyszące np. palenie tytoniu.
>> Przeczytaj również: Leniwe jelita – jak poprawić perystaltykę jelit?
Jakie są przyczyny nietolerancji węglowodanów?
Nietolerancja węglowodanów jest rodzajem nietolerancji pokarmowej, będącej niepożądaną reakcją na pokarm, w którą nie jest zaangażowany układ immunologiczny.
Przyczynami nietolerancji węglowodanów mogą być:
- niedobór enzymów trawiennych – może być wrodzony, spowodowany przez czynniki genetyczne lub nabyty;
- zaburzenia wchłaniania (zespół złego wchłaniania);
- dysbioza jelitowa;
- choroby jelit – choroba Leśniowskiego-Crohna, celiakia;
- nieprawidłowy styl życia – dieta, brak aktywności fizycznej.
Klasyfikacja nietolerancji węglowodanów
W zależności od rodzaju cukru, będącego źródłem problemu, możemy wyróżnić:
- nietolerancję laktozy,
- nietolerancję fruktozy,
- nietolerancję galaktozy,
- nietolerancję FODMAP – łatwo fermentujących i słabo wchłanianych węglowodanów, do których, oprócz wyżej wymienionych cukrów, zalicza się fruktany, galaktany i poliole.
Nietolerancja laktozy
Nietolerancja laktozy jest często spotykaną formą nietolerancji węglowodanów. Najmniejszą liczbę przypadków – 5-17% – stwierdza się wśród mieszkańców północnej części Europy, Ameryki Północnej i Australii. W Polsce może dotyczyć 20-37% populacji. Na południu Europy, np. w Grecji cierpi na nią ok. 45% dorosłych osób, w północnych Włoszech – 51%, na Sycylii i w Neapolu – do 80% populacji. Podobną częstość notuje się wśród mieszkańców Azji, np. 60-70% populacji Indii, 80-100 % Wietnamczyków.
Przyczyną zaburzonego wchłaniania laktozy jest brak lub zmniejszona synteza, powstającego w jelicie cienkim enzymu laktazy. Laktaza jest niezbędna do trawienia laktozy, bez działania tego enzymu cukier nie jest przetwarzany i – w postaci niezmienionej – przedostaje się do dalszych odcinków przewodu pokarmowego, wywołując wiele nieprzyjemnych w skutkach objawów.
>> Zobacz: Laktoza – co to jest i w czym występuje?
Najczęstszą przyczyną niedoboru laktazy jest tzw. niedobór pierwotny, który charakteryzuje się stopniowym spadkiem jej aktywności wraz z wiekiem. W okresie dziecięcym poziom laktazy jest z reguły w normie, zaczyna zmniejszać się z wieku młodzieńczym lub dorosłym. Dlatego objawy związane z zaburzeniami trawienia produktów mlecznych mogą pojawiać się w czasie dorastania lub u osób dorosłych. Zazwyczaj po upływie ok. 0,5 do 3 godzin od spożycia produktów zawierających laktozę pacjenci obserwują silne wzdęcia, gazy, biegunkę.
Rzadką postacią nietolerancji laktozy jest, uwarunkowany genetycznie, wrodzony niedobór laktazy, w którym objawy kliniczne pojawiają się już u noworodków.
| To ważne: Spadek aktywności laktazy z wiekiem stanowi fizjologiczne dostosowanie do diety uboższej w laktozę, w porównaniu z dietą dziecka. |
Nietolerancja laktozy może być również spowodowana chorobami przewodu pokarmowego, które uszkadzają jelito cienkie i prowadzą do upośledzenia wytwarzania laktazy. Należą do nich nieswoiste choroby zapalne jelit, celiakia, biegunki infekcyjne, niedożywienie. Wyleczenie lub remisja choroby podstawowej może prowadzić do unormowania się nietolerancji.
Diagnostyka nietolerancji laktozy opiera się na wykonaniu testu oddechowego, który jest opisany w dalszej części artykułu. Postać wrodzona nietolerancji potwierdzana jest badaniem genetycznym.
Leczenie polega na unikaniu produktów z laktozą. Większość pacjentów toleruje pewną ilość laktozy. Metaanaliza badań przeprowadzona w roku 2017 wykazała, że prawie wszystkie osoby z nietolerancją laktozy tolerują 12 g laktozy w jednym spożyciu i około 18 g dwucukru rozłożonego w ciągu dnia. Dlatego zazwyczaj nie ma potrzeby całkowitego eliminowania z diety produktów o niskiej zawartości laktozy, np. jogurtów.
>> Przeczytaj: Nietolerancja laktozy u niemowląt i dzieci: objawy, przyczyny, badania i leczenie

Nietolerancja fruktozy
Nietolerancja fruktozy to stan niepełnej absorpcji fruktozy pokarmowej przez błonę śluzową jelita cienkiego. Prowadzi to do gromadzenia się tego cukru w jelicie czczym oraz jelicie grubym. W rezultacie fruktoza ulega fermentacji w przewodzie pokarmowym, wywołując objawy brzuszne, takie jak nadmierna produkcja gazów, dyskomfort w jamie brzusznej, wzdęcia oraz zmiany motoryki, które wpływają na jakość życia pacjentów.
Nietolerancja fruktozy może być spowodowana zmniejszeniem powierzchni chłonnej jelit, zwiększoną motoryką jelit lub zaburzeniami procesu trawienia. Może być również powiązana z ograniczeniami w transporcie fruktozy przez ścianę jelit. Pełne wykorzystanie fruktozy przez przewód pokarmowy zależy od GLUT5 (Glucose Transporter 5) białka odpowiadającego za transport tego cukru przez błony komórkowe.
GLUT5 obecne jest głównie w jelitach, ale także w mięśniach, nerkach i tkance tłuszczowej, jego niedobór lub dysfunkcja prowadzi do nietolerancji fruktozy. Niemowlęta i małe dzieci o wysokim spożyciu fruktozy wykazują większą częstość występowania złego wchłaniania fruktozy, co można potencjalnie wyjaśnić rozwojowymi ograniczeniami ekspresji i regulacji GLUT5. Częstość występowania i nasilenie złego wchłaniania fruktozy u ludzi wydaje się zatem zmniejszać wraz z wiekiem.
Ocenia się, iż nietolerancja fruktozy jest obecnie problemem niedoszacowanym, który narasta. Wiąże się to faktem, iż historycznie fruktoza była spożywana tylko w określonych porach roku, w postaci owoców oraz miodu. Rozwój produkcji żywności na skalę przemysłową spowodował, iż jej spożycie – również w postaci syropu glukozowo-fruktozowego – znacznie wzrosło. Efektem tego zjawiska jest „przeciążenie” zdolności absorpcyjnej białka GLIU5 i niepełne wchłanianie fruktozy.
Nietolerancja fruktozy, oceniana jest na podstawie zawartości wodoru w wydychanym powietrzu w testach oddechowych. Stężenie wodoru wzrasta proporcjonalnie do stężenia fruktozy w diecie, zdolność do wchłaniania fruktozy jest indywidualna i różni się u zdrowych osób.
>> To ciekawe: Fruktoza w diecie dziecka

Fruktoza i jej wpływ na mikrobiotę jelitową
Dieta bogata we fruktozę wpływa na mikrobiotę jelitową u zwierząt doświadczalnych i ludzi. Badanie tego zjawiska u człowieka jest na etapie początkowym, ale pierwsze doniesienia pokazują różnice w zmianach składu mikrobioty w zależności od źródła pochodzenia fruktozy.
| Dieta bogata w owoce i warzywa | Fruktoza z syropu glukozowo-fruktozowego | |
| Zawartość błonnika | wysoka | niska |
| Zmiany w mikrobiocie | wzrost Faecalibacterium i Anaerostipes; spadek Parabacteroides i Barnesiella | spadek Ruminococcus, Faecalibacterium i Erysipelatoclostridium; wzrost Barnesiella |
| Wpływ na produkcję maślanu | stymulacja wzrostu bakterii produkujących maślan | zmniejszenie liczebności bakterii produkujących maślan |
| Wpływ na organizm | wsparcie homeostazy jelitowej i działanie przeciwzapalne | sprzyjanie stanom zapalnym jelit i naruszanie homeostazy |
Badanie pokazują, iż wpływ fruktozy na modulację mikrobioty nie jest jednolity i zależy od wielu czynników:
- stężenia fruktozy oraz czasu trwania ekspozycji;
- obecności innych składników, takich jak błonnik;
- uwarunkowań genetycznych
- wyjściowego profilu mikrobioty jelitowej;
- ogólnego wzorca żywieniowego i źródła pochodzenia cukru.
| Warto wiedzieć: Maślan, którego poziom zależy od rodzaju diety fruktozowej, stanowi główne źródło energii dla komórek jelita grubego, moduluje odpowiedź immunologiczną i pełni funkcje ochronne. |
Nietolerancja galaktozy – galaktozemia
Galaktozemia jest wrodzonym zaburzeniem metabolizmu galaktozy – cukru obecnego przede wszystkim w laktozie.
Trawienie galaktozy i jej przekształcanie w glukozę, wymaga enzymów: galaktokinazy (GALK), urydylilotransferazy 1-fosfogalaktozowej (GALT) i epimerazy UDP-galaktozy (GALE). Brak jednego z nich upośledza przemiany galaktozy, powodując jej odkładanie się w różnych tkankach i prowadząc do uszkodzenia ośrodkowego układu nerwowego, wątroby, nerek i soczewek oczu.
Galaktozemia jest uwarunkowana genetycznie. Najczęściej występuje niedobór GALT, rzadziej GALK lub GALE. Symptomy choroby są zauważalne u noworodka po rozpoczęciu karmienia, zarówno piersią, jak i mlekiem modyfikowanym.
W diagnostyce choroby pomocne są badania genetyczne. W rodzinach, w których występuje galaktozemia wskazane jest poradnictwo genetyczne przed planowaną ciążą.
Osoby dotknięte galaktozemią pozostają na diecie eliminacyjnej przez całe życie.
Nietolerancja FODMAPS
Nietolerancja FODMAPS (z ang. Fermentable Oligosaccharides, Disaccharides, Monosaccharides, And Polyols) to zaburzenia trawienia łatwo fermentujących węglowodanów, do których zalicza się np.:
- fruktany – pszenica, czosnek, cebula;
- galaktany – obecne w nasionach roślin strączkowych;
- poliole – znajdujące się w sztucznych środkach słodzących: sorbitolu, mannitolu, maltitolu, ksylitolu oraz w owocach pestkowych.
Nietolerancja sorbitolu
Sorbitol to naturalnie występujący poliol, który – jako E 420 – znajduje swoje zastosowanie np. w „bezcukrowych” słodyczach, gumach do żucia, napojach oraz w produktach dla diabetyków. Jest również obecny wielu gatunkach owoców, np. jabłkach, gruszkach, wiśniach, morelach i suszonych śliwkach.
W sytuacji fizjologicznej sorbitol wchłania się słabo, co powoduje, że jego nadmiar, nawet u zdrowych osób, może zatrzymywać płyn w świetle jelita grubego, wywołując biegunkę osmotyczną i działanie przeczyszczające. Badania pokazują, iż większość zdrowych ochotników spożywających 5 g sorbitolu nie wykazuje objawów nietolerancji, jednak podatność na biegunkę wywołaną poliolami różni się u poszczególnych osób. W jednym z badań wykazano, iż spożycie 10 g sorbitolu (dwie średnie gruszki lub pięć „bezcukrowych” miętówek) wywołuje dolegliwości żołądkowo-jelitowe u ok. 17% zdrowych uczestników, przy czym obserwowane objawy miały średniociężkie lub nawet ciężkie nasilenie.
Szczególnie podatne na ich występowanie są:
- osoby z zespołem jelita drażliwego (IBS), u których nawet dawka 5 g sorbitolu nie jest dobrze tolerowana
- pacjenci z nieswoistymi chorobami zapalnymi jelit (IBD), u których objawy żołądkowo-jelitowe mogą zaostrzać się nawet po spożyciu 3 g słodzika.
| Pamiętaj: U dzieci z dolegliwościami przypominającymi zespół jelita drażliwego należy brać pod uwagę nadmierne spożywanie sorbitolu w postaci „bezcukrowych” słodyczy (sorbitol), gum do żucia, napojów. |
Diagnostyka nietolerancji sorbitolu opiera się na teście oddechowym, w którym pacjent spożywa odpowiednią dawkę tej substancji, a następnie mierzy się zawartość wodoru i metanu w wydychanym powietrzu.

Objawy zespołu jelita drażliwego (ZJD) a nietolerancja węglowodanów
Objawy nietolerancji węglowodanów przypominają symptomy zespołu jelita drażliwego, co może opóźniać diagnostykę i przeprowadzenie testów.
Z drugiej strony około 60% pacjentów z IBS obserwuje nasilenia objawów po spożyciu pewnych pokarmów. Obserwacje kliniczne wskazują, iż szczególnie ważny jest związek tych objawów z nietolerancją węglowodanów FODMAP, w tym laktozy, fruktozy, sorbitolu. Pacjenci z IBS mogą tolerować zazwyczaj niższe dawki tych węglowodanów niż osoby zdrowe.
| Warto wiedzieć: Zdrowi ochotnicy zazwyczaj dobrze tolerują dawkę 5 g sorbitolu, podczas gdy u pacjentów z zespołem jelita drażliwego wywołuje ona objawy żołądkowo-jelitowe. |
Diagnostyka nietolerancji węglowodanów – testy oddechowe
W diagnostyce nietolerancji węglowodanów szczególne miejsce zajmują testy oddechowe.
W przebiegu nietolerancji i zalegania węglowodanów w jelicie dochodzi do wykorzystywania ich przez bakterie jelitowe. Końcowym produktem metabolizmu tych drobnoustrojów jest powstający w jelitach wodór i metan. Obydwa gazy przenikają do krwiobiegu i dostają się do płuc, skąd są wydychane z powietrzem.
Zawartość wodoru i metanu mierzona w wdychanym powietrzu koreluje z ilością węglowodanów w jelitach.
Za pomocą testów oddechowych można zdiagnozować nietolerancję laktozy, fruktozy i sorbitolu.
>> To również może Cię zainteresować: Testy oddechowe w diagnostyce chorób układu pokarmowego
Nietolerancja węglowodanów – jak się przygotować do testów?
Testy na nietolerancje pokarmowe należy wykonywać pojedynczo. Odstęp pomiędzy badaniami musi być min. 2 dni.
- Tydzień przed badaniem – jeśli będzie to tolerowane przez pacjenta lub uzgodnione z lekarzem – powinny być odstawione leki pobudzające perystaltykę przewodu pokarmowego, leki przeczyszczające.
- Obecnie brak wystarczających danych pozwalających na rekomendowanie odstawienia lub kontynuacji przyjmowania probiotyków i prebiotyków przed badaniem.
- Dzień przed badaniem pacjent powinien unikać pokarmów zawierających łatwo fermentujące węglowodany, potraw wzdymających, potraw z dużą ilością błonnika oraz słodzonych napojów.
- Badanie wykonywane jest na czczo – po 8-12 godzinach od ostatniego posiłku.
- Należy zrezygnować z przyjmowania witamin i suplementów diety rano przed wykonaniem testu.
- W dniu badania pacjent powinien wypić szklankę niegazowanej wody. Podczas badania dopuszczalne jest wypicie niewielkiej ilości wody.
- W dniu badania, w czasie przeprowadzania testu, pacjent nie powinien palić papierosów i unikać aktywności fizycznej.
- Nie można używać preparatów do mocowania protez zębowych w dniu badania. Można umyć zęby.
Przebieg badania
Przeprowadzenie badania jest proste i można to zrobić w domu. Wymaga jedynie specjalnego zestawu, który – wraz z instrukcją – można otrzymać w laboratorium.
W czasie badania pobiera się 10 próbek powietrza. Pierwsza próbka (wartość referencyjna) jest pobierana na czczo, przed wypiciem roztworu. Następnie przyjmuje się odpowiednią substancję testową (laktozę, fruktozę lub sorbitol) i powtarza pomiary co 20 minut.
W praktyce wygląda to następująco:
- pierwsza próbka – przed wypiciem roztworu.
- druga próbka – 20 minut po wypiciu roztworu.
- trzecia próbka – 40 minut po wypiciu roztworu.
- czwarta próbka – 60 minut – 1 godzina – po wypiciu roztworu.
- piąta próbka – 80 minut po wypiciu roztworu.
- szósta próbka – 100 minut po wypiciu roztworu.
- siódma próbka – 120 minut – 2 godziny – po wypiciu roztworu.
- ósma próbka – 140 minut po wypiciu roztworu.
- dziewiąta próbka – 160 minut po wypiciu roztworu.
- dziesiąta próbka – 180 minut – 3 godziny – po wypiciu roztworu.
| To ważne: Przy posługiwaniu się urządzeniami do pobierania próbki należy zwracać uwagę, aby nie wkładać palca do wnętrza urządzenia do pobierania próbki. Znajduje się tam ostra igła. Istnieje niebezpieczeństwo zranienia! |
U pacjentów z cukrzycą należy uwzględnić ilość spożywanych węglowodanów – wykonanie testu powinno być skonsultowane z lekarzem.
Nietolerancja węglowodanów – leczenie
Leczenie nietolerancji węglowodanów polega na unikaniu produktów, które zawierają nietolerowany przez danego pacjenta cukier. Nie ma uniwersalnej diety w nietolerancji węglowodanów, jej skład zależy od czynnika wywołującego chorobę oraz ewentualnych chorób towarzyszących. Dlatego pacjent z nietolerancją powinien być pod opieką dietetyka, który ułoży odpowiednie menu. Nie należy samodzielnie wykluczać z diety pewnych produktów, ponieważ może to prowadzić do niedoboru ważnych składników pokarmowych. Dietetyk wskaże co można i należy jeść, jakich produktów unikać i jakie zamienniki zastosować.
Czy eliminacja węglowodanów z diety jest konieczna?
Wiele osób – pomimo nietolerancji – może spożywać niewielkie ilości węglowodanów, dlatego nie zawsze całkowita ich eliminacja jest konieczna. Odpowiednie menu, uwzględniające indywidualne potrzeby pacjenta, pomoże opracować dietetyk.
Zakończenie
Nietolerancja to częsty problem zdrowotny, z tendencją do narastania. Wzrost zachorowań (szczególnie na nietolerancję fruktozy i sorbitolu) jest skorelowany z nowoczesną dietą, bogatą w żywność przetworzoną i produkty z użyciem syropu glukozowo-fruktozowego.
Utrata zdolności trawienia węglowodanów może być procesem naturalnym (zanik laktazy z wiekiem), może być również efektem uszkodzenie jelit w przebiegu chorób czy infekcji lub rzadziej – wrodzonego defektu genetycznego. Najczęstsze objawy nietolerancji węglowodanów do zaburzenia żołądkowo-jelitowe: wzdęcia, gazy, biegunka.
W diagnostyce nietolerancji węglowodanów ważne miejsce zajmują testy oddechowe, do których pacjent musi się odpowiednio przygotować. Leczenie polega na zastosowaniu indywidualnej diety i optymalizacji żywienia przy pomocy dietetyka, co pozwoli na unikanie niepotrzebnych restrykcji i niedoborów pokarmowych.
Nietolerancja węglowodanów – FAQ
Nietolerancja węglowodanów nie jest alergią, w powstawanie tych schorzeń nie jest zaangażowany układ immunologiczny.
Nie występuje alergia na węglowodany. Mianem alergii często określane są nietolerancje węglowodanów.
Głównymi metodami diagnostycznymi pozwalającymi na określenie nietolerancji węglowodanów są wodorowo-metanowe testy oddechowe.
Piśmiennictwo
- Toca M.D.C., Fernández A., Orsi M. i in. Lactose intolerance: myths and facts. An update. Arch Argent Pediatr, 2022, 120(1), 59-66
- Fernández-Bañares F. Carbohydrate Maldigestion and Intolerance. Nutrients. 2022 May 4;14(9):1923. doi: 10.3390/nu14091923. PMID: 35565890; PMCID: PMC9099680.
- Zingone F., Bertin L., Maniero D. i in. Myths and Facts about Food Intolerance: A Narrative Review. Nutrients, 2023, 15(23), 4969
- Recent advances on lactose intolerance: Tolerance thresholds and currently available answers. Corgneau M, Scher J, Ritie-Pertusa L, Le DTL, Petit J, Nikolova Y, Banon S, Gaiani C. Crit Rev Food Sci Nutr. 2017 Oct 13;57(15):3344-3356. doi: 10.1080/10408398.2015.1123671.
- Szostak-Węgierek D.: Występowanie hipolaktazji u dzieci w wieku szkolnym w Warszawie. Pediatr. Pol. 1999; 4; 13–17.
- Fedewa A, Rao SS. Dietary fructose intolerance, fructan intolerance and FODMAPs. Curr Gastroenterol Rep. 2014 Jan;16(1):370. doi: 10.1007/s11894-013-0370-0. PMID: 24357350; PMCID: PMC3934501.
- Simões CD, Sousa AS, Fernandes S, Sarmento A. Fructose Malabsorption, Gut Microbiota and Clinical Consequences: A Narrative Review of the Current Evidence. Life. 2025; 15(11):1720. https://doi.org/10.3390/life15111720
- Lee JY, Tiffany CR, Mahan SP, Kellom M, Rogers AWL, Nguyen H, Stevens ET, Masson HLP, Yamazaki K, Marco ML, Eloe-Fadrosh EA, Turnbaugh PJ, Bäumler AJ. High fat intake sustains sorbitol intolerance after antibiotic-mediated Clostridia depletion from the gut microbiota. Cell. 2024 Feb 29;187(5):1191-1205.e15. doi: 10.1016/j.cell.2024.01.029. Epub 2024 Feb 15. PMID: 38366592; PMCID: PMC11023689.
- Shepherd SJ, Parker FC, Muir JG, Gibson PR. Dietary triggers of abdominal symptoms in patients with irritable bowel syndrome: randomized placebo-controlled evidence. Clin Gastroenterol Hepatol. 2008 Jul;6(7):765-71. doi: 10.1016/j.cgh.2008.02.058. Epub 2008 May 5. PMID: 18456565.
- Guzek M., Borys B., Sulkowska A., Smoczyński M., Rola nietolerancji pokarmowych w powstawaniu objawów zespołu jelita nadwrażliwego u dorosłych, Forum Medycyny Rodzinnej 2011, tom 5, nr 3, 239–246.